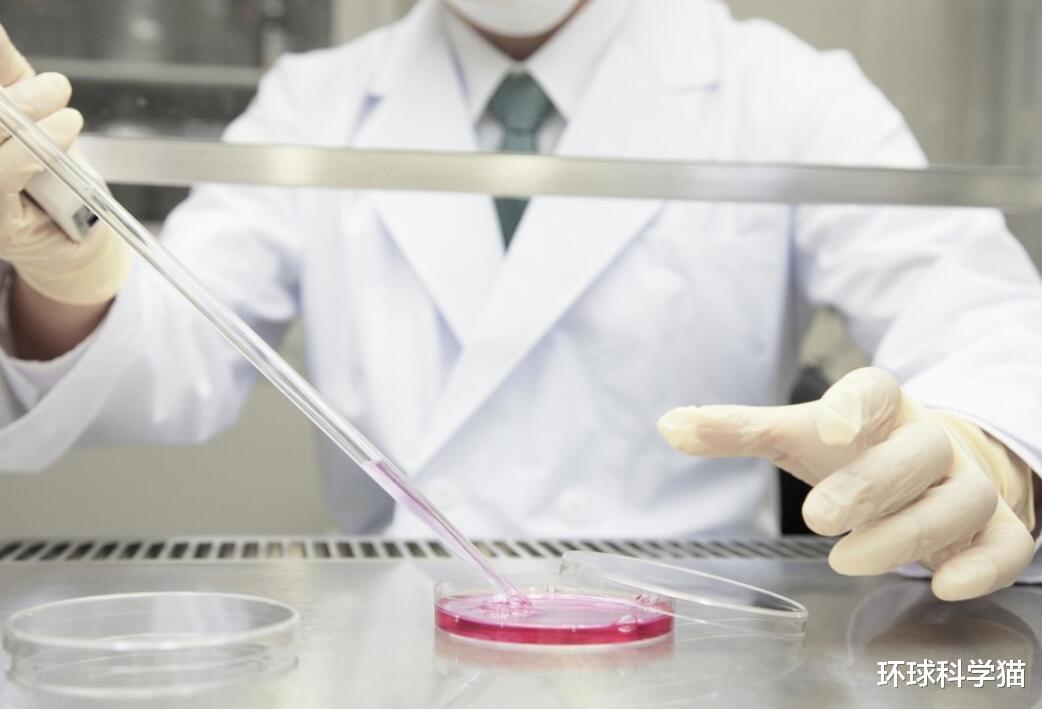
基因 科幻变成现实?美国秘密计划被爆出!改变人体基因,创造超人细胞

【基因|科幻变成现实?美国秘密计划被爆出!改变人体基因,创造超人细胞】
文章图片

文章图片
文章图片

文章图片

文章图片
地球是人类赖以生存的天体 , 是“无法替代”的 , 虽然如今人类在加大对“第二地球”的探索 , 但是能够找到与地球一模一样地“天体”真的就是“大海捞针” , 基本上是不太可能的 , 并且至今人类也还未发现一颗适合“人类”居住的地外天体 , 所以相对地球来说 , 短时间地球还是“人类”唯一可以居住的天体 。
不过如今全球也在实施“火星移民计划” , 希望将火星改变能成为“第二地球” , 有没有这个可能性暂时不清楚 , 但是人类如今正在实施“改变”计划 , 所以未来“火星”有概率成为人类的“第二地球” 。 然而如今NASA科学家们又爆出了美国一个新计划 , 有点超乎大家的想象 。
改造人类基因 , 适应地外天体
基因工程理解其实很容易 , 我们又称基因拼接技术、DNA重组技术 , 相当于是对人类的原始基因进行改变 , 然后达到某种目的 。 也就是——以改变生物原有的遗传特性、获得新品种、生产新产品的遗传技术 。 不过这种技术的改变对人类来说 , 基本上是“禁止使用”的 , 然而如今“改造人类基因”又被提出来了 , 这是一个可怕的消息 。
这次又是美国!根据外媒报道 , 美国宇航局(NASA)一名科学家表示 , 如果人类想要在其他星球上移民 , 就需要改变自身的身体 , 并且他已经成功迈出了第一步 。 然而说出这个话的人 , 是来自康奈尔大学 , 是一位遗传学教授 , 名叫克里斯·梅森(Chris Mason) , 他是NASA测量太空旅行对人体影响“twin project”项目的重要参与者 。
这说明什么?美国已经启动了“改造人类基因”的计划 , 那适应未来的情况 , 那这就是不太好了 , 人类一直比较反对“人类基因改造”工程 , 而如今美国又是来提前做这个事情 。 如果不是这一位NASA科学家说出来 , 是不是大家又被美国“蒙在鼓里”了 , 完全不知道 , 至少我之前从未看到美国提到过 。 而这项计划的目的是“成功后将能够在外星生存” 。
科幻变现实 , 人类将成为“外星人”?
从现有的情况来看 , 美国的这项计划还在实施之中 , 地球的环境都知道 , 我们完全能够适应 , 但是对于外太空环境来说 , 就如火星来讲 , 面临的高辐射、极端性的恶劣环境等是必不可少的 , 所以人类要想在这样的环境之下 , 肯定要改变人体才可能适应下来 , 所以在人类没有办法改变地外天体的情况之下 , 那就是改变人类自己 。
然而美国被曝的“秘密计划” , 如今正在实施了 。 根据NASA科学家 , 项目参与者克里斯·梅森(Chris Mason)表示 , 如今开始试验性地修改人类的太空飞行基因 , 以建立分子基础和基因防御系统来实现人类长期太空旅行的亚基因组 。 同时还表示 , 他挑选了一种几乎无法被杀死的缓步动物DNA元素 , 用来创造一种“超人细胞” 。 该基因名为Dsup , 通过这个DNA改变太空之中所受到的伤害 。
同时在实验之中 , 克里斯已经将Dsup永久地整合到人类基因组和一个新细胞系中 。 当向这些细胞发射强辐射时 , 与普通细胞相比 , 新细胞能够将损伤降低80% 。 所以“超人细胞”正在培育之中 。 一旦这个成功了 , 那么人类将真正地成为“外星人” 。 这项计划可以说美国隐藏太深了 , 之前根本没有大规模提出过 。
如今这一位NASA科学家爆出来 , 到底有没有什么目的 , 暂时不清楚 , 但是只要出现基因改变的情况 , 就可能带来“意外”的出现 , 所以美国这项“秘密计划”是否符合科学界的要求 , 这个可能还会出现一定的争议性 。 但是如今正在进行之中 , 那后面会发生什么 , 我们也是难以想到的 。
所以才美国正在研究“超人细胞” , 如果这项计划没有得到科学界的反驳 , 那必然未来可能出现“外星人类” , 这似乎都成为了科幻片了一样 , 人类正在朝科幻作品之中的模式发展一样 。 当然成不成我们不知道 , 但是美国这项计划确实在实施了 。
推荐阅读
- 揭秘陶乐德事件:男子在拘留室离奇消失,难道平行时空真的存在?
- 青藏高原将停止增高,后果不可承受,我们却未感到危机
- 关于鹦鹉螺的知识,造型可爱的‘活化石’
- 地球冷却速度远超预期!或成为第二个火星,人类应该何去何从?
- 人类还会再进化吗?会进化成什么样子?
- 寻求气候变化的确定性:要多少才足够?
- “九星连珠”后地球会怎样?科学家已测出时间,距上次刚好1000年
- 少见!今年十五的月亮,不是十六圆
- 科学家在大型强子对撞机上寻找难以捉摸的基本粒子
- 为人类敲响警钟!57000年前的尸体重见天日,史前生物现身引发关注
